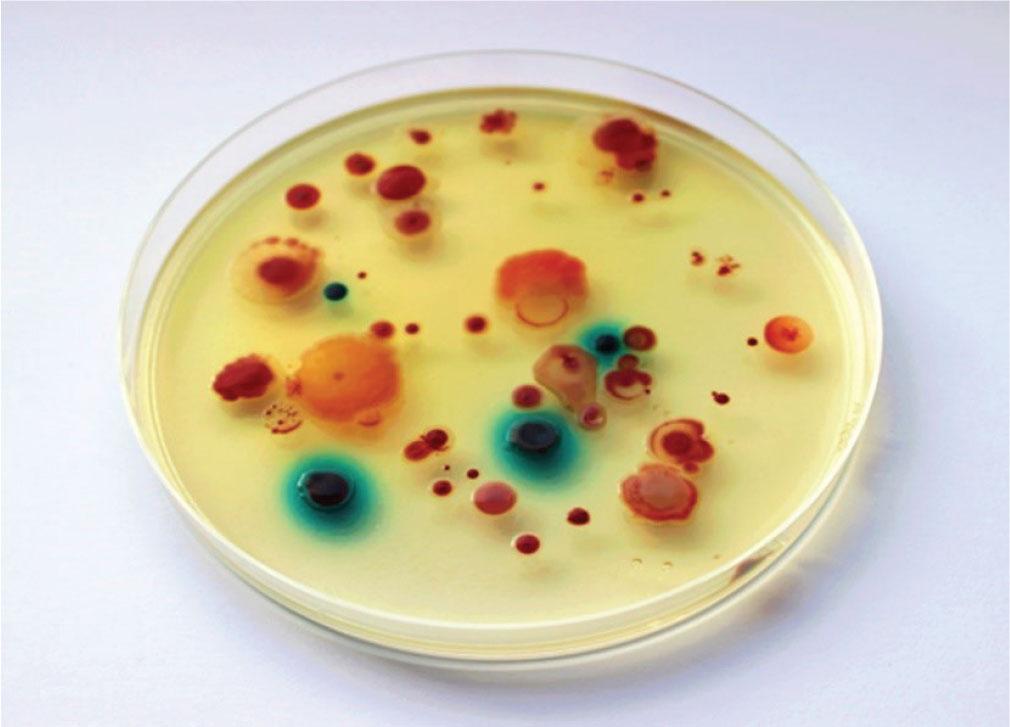

Figure 1
Figure 2

Figure 3

Figure 4

Minimum inhibitory concentrations (MIC) of imipenem, meropenem, and ertapenem according to EUCAST (48) and CLSI (49) criteria for clinically relevant CRE, CRA, and carbapenem-resistant P_ aeruginosa
MIC values (mg/mL) | ||||||
---|---|---|---|---|---|---|
Enterobacterales | Acinetobacter spp. | Pseudomonas spp. | ||||
EUCAST | CLSI | EUCAST | CLSI | EUCAST | CLSI | |
Imipenem | S≤2 | S≤1 | S≤2 | S≤2 | S≤0.001 | S≤22 |
R>4 | R≥4 | R>4 | R≥8 | R>4 | R≥82 | |
Meropenem | S≤21 | S≤1 | S≤21 | S≤2 | S≤21,2 | S≤22 |
R>81 | R≥4 | R>81 | R≥8 | R>81,2 | R≥82 | |
Ertapenem | S≤0.5 | S≤0.5 | - | - | - | - |
R>0.5 | R≥2 | - | - | - | - | |
Doripenem | S≤1 | S≤1 | S ≤0.001 | S≤2 | S≤0.001 | S≤22 |
R>2 | R≥4 | R>2 | R≥8 | R>2 | R≥82 |
Literature reports of CRB presence in different environmental samples
Species | Sample type | Reference |
---|---|---|
A. baumannii, Enterobacterales | Hospital environment (sheets, bed rail, bedside table, keyboard, devices, ventilator tube, air sample, air conditioner, sheets and infusion pump) | (88,89,90, 92, 93) |
K. pneumoniae, A. baumannii, P. aeruginosa | Hospital sewage | (44, 95, 96) |
K. pneumoniae, A. baumannii, P. aeruginosa | Urban sewage | (96, 97) |
K. pneumoniae, A. baumannii, Pseudomonas sp. | River water and sediment | (30, 32, 104, 126) |
Klebsiella spp., Acinetobacter spp., Pseudomonas spp. E. coli | Sea water and sediment | (109, 110) |
E. asburiae | Lake water | (108) |
A. baumannii | Soil | (111) |
K. pneumoniae, A. baumannii, E. cloacae | Hospital WWTP | (98, 102) |
K. pneumoniae, A. baumannii, E. coli | Urban WWTP | (43, 100) |
A. baumannii, E. coli | Companion animals | (113, 115) |
K. pneumoniae | Domestic animals | (118) |
K. pneumoniae, A. baumannii, E. coli | Ready-to-eat vegetables | (121, 122) |